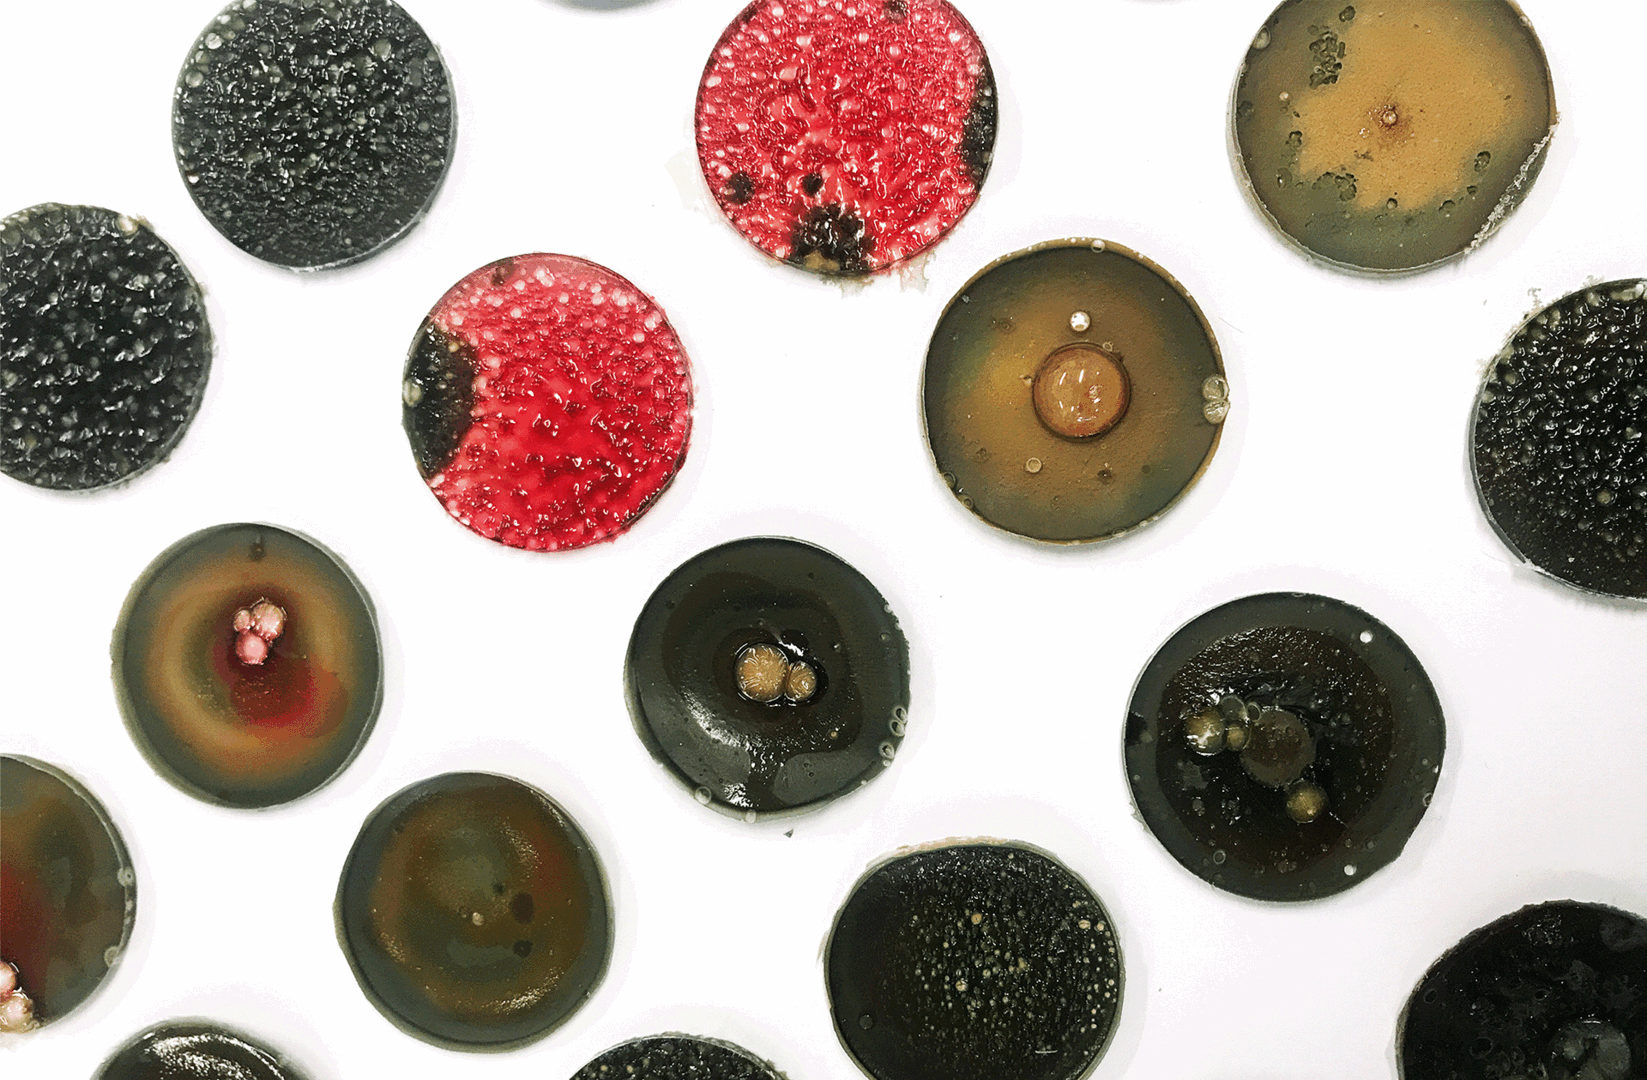
Time Pieces_Chronomaterials SMALL

Hazal's werk wordt gedreven door een grote verantwoordelijkheid voor de natuur en ‘meer dan menselijk’. Ze streeft ernaar de grenzen van onze huidige realiteit te verleggen en het publiek te boeien door hen mee te nemen naar nieuwe werelden om zich alternatieve manieren van leven voor te stellen en te overwegen die diversiteit, gelijkheid en inclusie bevorderen. XR belooft grenzeloze mogelijkheden voor meeslepende verhalen, interactieve ervaringen en transformatieve technologieën.
Ze ziet XR als een krachtig middel om het onzichtbare zichtbaar te maken voor sociale impact en positieve verandering en XR te gebruiken om radicale toekomsten zichtbaar en ervaarbaar te maken om het bewustzijn en begrip van verschillende perspectieven te vergroten, empathie te bevorderen en uiteindelijk zinvolle verbindingen te bevorderen, zinvolle maatschappelijke transformaties te stimuleren en de manier waarop we omgaan met natuur en technologie te transformeren.